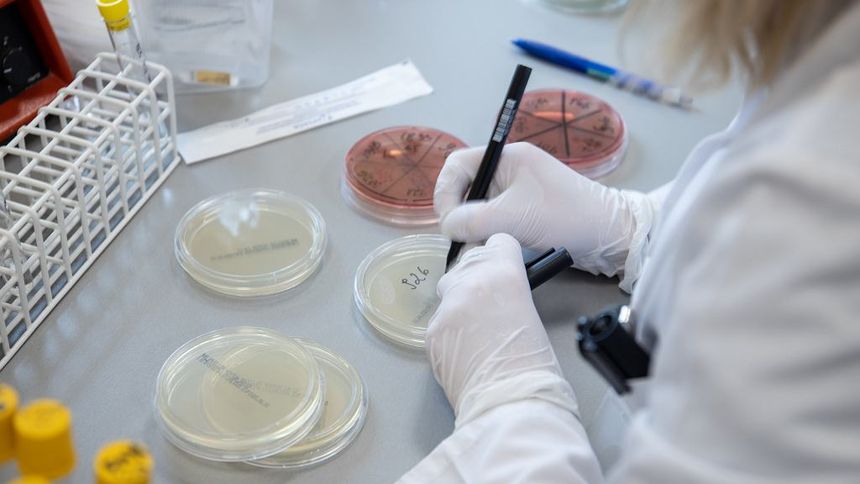
|

Krajowa Rada Diagnostów Laboratoryjnych reaguje na serial "Podziemie". "Dzisiaj złożę zawiadomienie do Rzecznika Odpowiedzialności Zawodowej"
Trzeci odcinek serialu dokumentalnego "Podziemie" o niepotwierdzonych naukowo procedurach leczenia boreliozy ujawnia, że podziemie oprócz własnych lekarzy ma też własne laboratoria. Diagnozują one przenoszone przez kleszcze choroby, których nikt inny nie potrafi potwierdzić. Na ich podstawie pacjenci całymi latami przyjmują leki. Dziennikarz TOK FM Michał Janczura jedzie do Świnoujścia, gdzie stwierdza się wyjątkowo liczne przypadki babeszjozy u ludzi. Dociera do diagnosty Andrzeja Janowicza, który przyjmuje pacjentów w siedzibie biura podróży i wyjaśnia, że osobista wizyta nie jest wcale potrzebna. Okazuje się, że pacjent sam może sobie pobrać krew, a następnie wysłać ją pocztą. Do koperty ma też włożyć pieniądze za badanie. Choć możliwa jest również zapłata przelewem. Dziennikarz TOK FM ustalił, że w Świnoujściu jeszcze jedna osoba diagnozuje babeszjozę u pacjentów z całej Polski. To córka Andrzeja Janowicza.
To nie wszystko, co mamy dla Ciebie w TOK FM Premium. Spróbuj, posłuchaj i skorzystaj z oferty 'taniej na zawsze'. Wejdź tutaj, by znaleźć szczegóły >>
Na informacje przedstawione w materiale Michał Janczury zareagowała Krajowa Rada Diagnostów Laboratoryjnych. Jak poinformowała nas prezeska Monika Pintal-Ślimak dzisiaj zostanie złożone zawiadomienie do Rzecznika Odpowiedzialności Zawodowej Krajowej Izby Diagnostów Laboratoryjnych w związku z podejrzeniem popełnienia przewinienia zawodowego przez osoby, których nazwiska zostały ujawnione w audycji.
– Stoimy po tej samej stronie mocy. Każda nieprawidłowość powinna być wyjaśniona, bo jest to w naszym interesie i będziemy to robić – podkreśliła w TOK FM Monika Pintal-Ślimak.
– Diagnostyka laboratoryjna to szeroka gałąź laboratoryjna, a to, co przedstawiliśmy, to nie jest raczej norma, a pewne anomalie, które się zdarzają – powiedział autor serialu. I tak też uważa prezeska Krajowej Rady Diagnostów Laboratoryjnych, która podkreśliła, że 'to niewielki promil wśród diagnostów, który wymaga wyjaśnienia'. – Z punktu widzenia samorządu zawodowego, który ma konstytucyjne i ustawowe zadanie stania nad pieczą i należytym wykonywaniem zawodu, uważam, że każda nieprawidłowość powinna być wyjaśniona. To jest zarówno w naszym interesie, jak i samorządów zawodowych – mówiła Monika Pintal-Ślimak.
Nie badajmy kleszcza
Prezeska poinformowała, że Krajowa Rada Diagnostów Laboratoryjnych powołała komisję ds. parazytologii (nauka zajmująca się badaniem pasożytów), która razem z zespołem ds. mikrobiologii medycznej, wydały negatywną opinię na temat wykonywania badań kleszczy na obecność patogenów chorób transmisyjnych (wirusów, bakterii, pasożytów) w medycznych laboratoriach diagnostycznych.
- Chciałabym podkreślić, że w laboratoriach wykonujemy badania z materiału biologicznego człowieka. A nie kleszcza. Wyniki otrzymane tą metodą nie mogą być wykorzystywane w celu diagnostycznym– relacjonowała Monika Pintal-Ślimak.
Jednocześnie, gościni TOK FM, jako prezes Krajowej Rady Diagnostów Laboratoryjnych, skierowała zapytanie do konsultantów w dziedzinie chorób zakaźnych, konsultanta w dziedzinie medycyny laboratoryjnej czy Polskiego Towarzystwa Epidemiologów, czy znają to badanie i czy ono jest rekomendowane. – Wszyscy specjaliści odparli, że to badanie jest nierekomendowane. Mamy więc poparcie stanowiska Krajowej Rady Diagnostów Laboratoryjnych – wyjaśniła przedstawicielka diagnostów laboratoryjnych.
– Nie badamy kleszcza. Jeżeli słuchają nas pacjenci, chciałabym, żeby to wybrzmiało, że to jest niepotrzebne wydawanie pieniędzy na tego typu badania. I taką też informację przekazaliśmy do Rzecznika Praw Pacjenta, do NFZ i myślę, że efektem państwa pracy jest to, że NFZ prowadzi taką kampanię wśród pacjentów – podkreśliła.
Prezeska KRDL dodała, że diagności laboratoryjni powinni opierać się na rekomendacjach wydawanych przez towarzystwa naukowe, zarówno medycyny laboratoryjnej, jak i lekarskiej dotyczących stosowanych metod badawczych i metod leczniczych. - Do tego zobowiązują nas przepisy prawa, ale także kodeks etyki. (?) Każdy diagnosta laboratoryjny powinien wykonywać swoją pracę zgodnie z aktualną wiedzą medyczną i nią się kierować – powiedziała na koniec gościni Michała Janczury.






![Szpital w Lubaniu [zdjęcie ilustracyjne] Szpital w Lubaniu [zdjęcie ilustracyjne]](https://s.eurozet.pl/cbz/2026/06/22/200c170b/2274520-120x68-3bef94b0e8.jpg)























